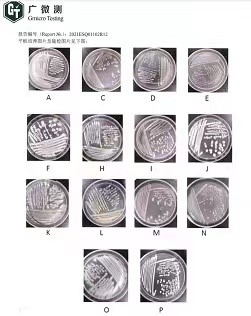

一、产品介绍
土壤修复,也称土壤污染治理,是指通过物理、化学或生物技术,移除、降解、转化或固定土壤中的污染物,使其浓度降低到可接受的安全水平,恢复土壤生态功能,保障人体健康与环境安全的过程。在土壤修复行业,已有的土壤修复技术达到一百多种,常用技术也有十多种,大致可分为物理、化学和生物三种方法。
二、工作原理
土壤修复的工作原理本质上是针对污染物特性,采用物理、化学或生物方法,实现污染物的去除、破坏或无害化。
物理分离与转移:通过换土、加热(热脱附)或抽气(气相抽提)等方式,直接将污染物从土壤中分离并移除。
化学转化与固定:向土壤注入氧化剂、还原剂或固化剂,将有毒污染物分解为无害物质,或将其化学形态固定,阻止其迁移和被生物吸收。
生物吸收与降解:利用特定植物(植物修复)吸收富集污染物,或通过土著/外源微生物(微生物修复)的代谢活动,将有机污染物降解为水和二氧化碳等。
修复技术的选择与组合,取决于污染物的种类、浓度、土壤性质及修复目标(如快速开发或生态恢复),核心是阻断污染物在“土壤-水-植物-人体”链中的暴露途径,恢复土地安全利用价值。
三、设备优点
土壤修复的核心优点在于实现风险管控、资源再生与永续发展。它能彻底消除污染物对健康和生态的威胁,阻断其向水、气扩散。通过使污染土地重获安全使用价值(如变工业棕地为住宅或公园),释放巨大经济潜力。特别是生物修复等技术,兼具成本效益与生态友好性,以最小环境代价实现土地的可持续利用。土壤修复可以改善土壤结构与功能,阻断生态链污染扩散,提升耕地生产力指标。对于维护生态平衡、保障食品安全、促进可持续发展以及保护水资源等方面具有重要意义。
上一篇:没有了!
下一篇:没有了!
达标保障
承诺所销售的设备确保达标。如经过三次验收后依旧不达标,我们将全额退款并按设备总价款的20%支付误工费。
48小时无理由退货1、已付定金:如客官已支付定金,客官可以在支付定金之日起48小时内取消订单,我们会在一个工作日内进行确认并审核,审核无误后我们会在两个工作日内将定金返回至您的相关银行账户;
2、货到付款:如客官选择的是货到付款,设备运送至约定地点后48小时内仍可选择无理由退货,您仅需负责设备的往返运输费用。
价格保护
客官可在成功下单后3个工作日内申请价格保护,申请成功后,可按购买售价进行支付。
温馨提示: 1、价格保护有效期为自申请之日起30天内。
2、优惠活动的商品不参与价格保护。
一站式服务
1、卸货验收设备运送至现场后协助客官检查验收。
2、我们将派员至现场指导您安装调试,确保污水处理100%达标。
3、享受免费技术服务。
申请条件及范围
客官提出"无理由退货"服务申请的条件:
1、客官在签收设备前发起申请;
2、客官的申请在形式上符合相关法律法规的规定;
3、申请退货款金额仅以客官实际支付的商品价款为限;
4、客官提出"无理由退货"服务申请的商品需满足相关条件;
无理由退货时间和范围
1、如果预先支付定金,自定金支付之日起48小时内;
2、如果选择货到付款,设备运输至指定地点后48小时之内;
3、现场安装并多次调试后设备不达标;
无理由退货申请流程
1、在满足无理由退货申请条件的前提下,客官可拨打我们的24小时客服热线:400-608-1238申请;
2、在收到客官"无理由退换货"申请后,我们会在收到申请之日起两个工作日内进行确认并处理;
3、如非因设备质量问题,客官以无理由形式退货或拒签的,来回运费均由客官承担;
温馨提示
1、验收设备时请客官仔细检查货品和送货单与客官系统订单是否一致,确认无误后验收;
2、如客官已验收或由他人代为验收,则视为设备外观及型号等无误,货物验收后我们将无法受理此类问题;
3、设备图片及信息仅供参考,不属产品质量问题;因拍摄灯光及不同显示器色差等问题可能造成图片与实物有微小出入,一切以实际货物为准;
4、若客官已开具增值税发票,在设备退货时请与我们客服联系,咨询增值税发票的退货注意事项;
1、全国联保,扫描维修保障二维码立即获得售后服务;同时也可网上报修,在线提交售后服务申请单,我们的工作人员会尽快审核确认并指导客官进行后续处理。
2、7日×24小时工作制:
旭日东售后服务时间:周一至周日,全天24小时待命。
3、热线咨询服务:
在产品保修期内,如果客官有售后问题需要咨询,欢迎客官拨打我们的24小时客服热线:400-608-1238。
4、在线咨询服务:
如果客官有问题需要咨询,可以联系山在线客服。
服务时间:7:30—22:00
5、售后服务处理周期
退货处理周期,自接收到问题商品之日起2个工作日内为客官处理完成;
换货处理周期,自接收到问题商品之日起30日之内为客官处理完成;
正常维修处理周期,自接收到问题商品之日起7日内为客官处理完成。
详情请咨询:400-608-1238